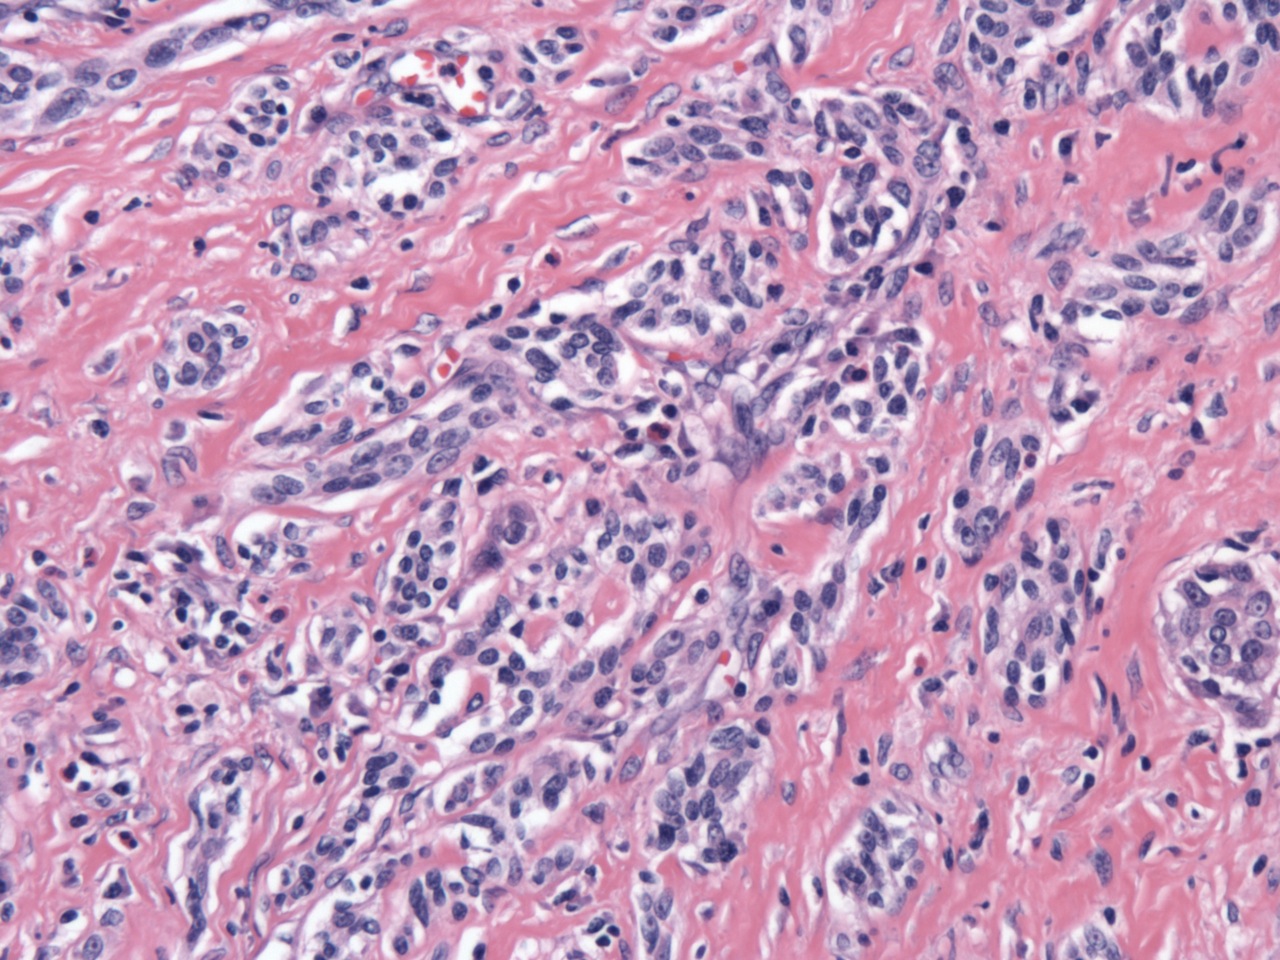

25 January 2012 - Case #230
All cases are archived on our website. To view them sorted by case number, diagnosis or category, visit our main Case of the Month page. To subscribe or unsubscribe to Case of the Month or our other email lists, click here.
This case was contributed by Dr. Hillary Kimbrell, Tulane University School of Medicine, Louisiana, USA.
Case #230
Clinical history:
Middle aged woman with locally recurrent thyroid tumor, which was biopsied.
Microscopic images:
What is your diagnosis?
Diagnosis: Sclerosing mucoepidermoid carcinoma with eosinophilia
Discussion:
Sclerosing mucoepidermoid carcinoma with eosinophilia is a rare thyroid malignancy seen almost exclusively in adult women, with a female:male ratio of 17:1 (Mod Pathol 2000;13:802). The tumor is composed of nests and anastomosing cords of relatively bland epidermoid cells with prominent nucleoli in a densely sclerotic stroma. Intermixed mucous cells can range from rare (as in this case) to abdundant and some cases may have mucous cysts. Areas of squamous differentiation with keratin pearls can be seen. The stroma contains a mixed inflammatory infiltrate with numerous eosinophils. Perineural invasion and obliteration of blood vessels are typical features and perithyroidal soft tissue is involved in about half of the cases.
In patients with sclerosing mucoepidermoid carcinoma with eosinophilia, the background thyroid invariably shows chronic lymphocytic thyroiditis. It has been speculated that this tumor arises from ultimobranchial body rests (also known as solid cell nests), which are often hyperplastic in severe chronic thyroiditis (Mod Pathol 2000;13:802). In keeping with this theory, the tumor cells in sclerosing mucoepidermoid carcinoma with eosinophilia are negative for both thyroglobulin and calcitonin; TTF1 is negative in most cases (Mod Pathol 2004;17:526). Further, sclerosing mucoepidermoid carcinoma with eosinophilia is diffusely positive for p63, which is also positive in ultimobranchial bodies and negative in follicular cells.
A BRAF V600E mutation has been identified in solid cell nests adjacent to a papillary thyroid carcinoma, which supports the idea that solid cell nests may give rise to thyroid malignancies (Hum Pathol 2009;40:1029); however, the WHO believes that sclerosing mucoepidermoid carcinoma arises from follicular epithelium derived metaplastic squamous nests. Rarely, these tumors are associated with a conventional papillary thyroid carcinoma.
This is generally an indolent malignancy; approximately one - third of cases have regional lymph node metastases and rarely lung and bone metastases occur (DeLellis: Pathology and genetics of tumours of endocrine organs, 1st Edition, 2004). This patient had several local recurrences over the course of a decade and eventually required a laryngectomy because of airway compromise.
All cases are archived on our website. To view them sorted by case number, diagnosis or category, visit our main Case of the Month page. To subscribe or unsubscribe to Case of the Month or our other email lists, click here.
This case was contributed by Dr. Hillary Kimbrell, Tulane University School of Medicine, Louisiana, USA.
The USCAP Long Course issue
The USCAP Long Course issue is comprised of lectures reviewing diagnostic criteria, application of ancillary tests including new molecular assays, and clinical significance of diagnosis and classification of common and uncommon lung diseases. Topics will include practical advice on interpreting both small biopsy samples and larger surgical specimens. This current issue is a comprehensive update of pulmonary pathology led by experts in the field, focusing on diagnostic challenges in the surgical pathology of both neoplastic and non-neoplastic lung diseases.
Click here to access select articles from the USCAP Long Course issue for the next three weeks only.
Advertisement [#2770]
Case #230
Clinical history:
Middle aged woman with locally recurrent thyroid tumor, which was biopsied.
Microscopic images:
What is your diagnosis?
Click here for diagnosis and discussion:
Diagnosis: Sclerosing mucoepidermoid carcinoma with eosinophilia
Discussion:
Sclerosing mucoepidermoid carcinoma with eosinophilia is a rare thyroid malignancy seen almost exclusively in adult women, with a female:male ratio of 17:1 (Mod Pathol 2000;13:802). The tumor is composed of nests and anastomosing cords of relatively bland epidermoid cells with prominent nucleoli in a densely sclerotic stroma. Intermixed mucous cells can range from rare (as in this case) to abdundant and some cases may have mucous cysts. Areas of squamous differentiation with keratin pearls can be seen. The stroma contains a mixed inflammatory infiltrate with numerous eosinophils. Perineural invasion and obliteration of blood vessels are typical features and perithyroidal soft tissue is involved in about half of the cases.
In patients with sclerosing mucoepidermoid carcinoma with eosinophilia, the background thyroid invariably shows chronic lymphocytic thyroiditis. It has been speculated that this tumor arises from ultimobranchial body rests (also known as solid cell nests), which are often hyperplastic in severe chronic thyroiditis (Mod Pathol 2000;13:802). In keeping with this theory, the tumor cells in sclerosing mucoepidermoid carcinoma with eosinophilia are negative for both thyroglobulin and calcitonin; TTF1 is negative in most cases (Mod Pathol 2004;17:526). Further, sclerosing mucoepidermoid carcinoma with eosinophilia is diffusely positive for p63, which is also positive in ultimobranchial bodies and negative in follicular cells.
A BRAF V600E mutation has been identified in solid cell nests adjacent to a papillary thyroid carcinoma, which supports the idea that solid cell nests may give rise to thyroid malignancies (Hum Pathol 2009;40:1029); however, the WHO believes that sclerosing mucoepidermoid carcinoma arises from follicular epithelium derived metaplastic squamous nests. Rarely, these tumors are associated with a conventional papillary thyroid carcinoma.
This is generally an indolent malignancy; approximately one - third of cases have regional lymph node metastases and rarely lung and bone metastases occur (DeLellis: Pathology and genetics of tumours of endocrine organs, 1st Edition, 2004). This patient had several local recurrences over the course of a decade and eventually required a laryngectomy because of airway compromise.